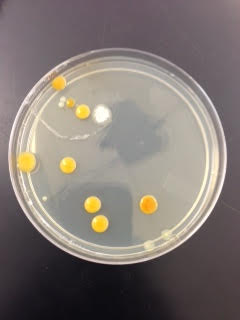
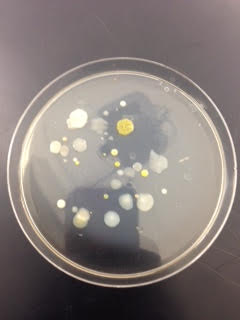

User:Libin G. Abdi/Notebook/Biology 210 at AU
2.20.15 Excellent Invertebrate and Vertebrate entries Well presented data and nice detailed description of Berlese funnel methods. Nice food web. Considers the fence surrounding your transect. Well organized. SK
Feb.26, 2015 - Zebrafish Development: Days 7 and 11
Purpose:This was a continuation of the zebrafish experiment.
Methods and Materials: Like before, stage of development, length (in mm), and number of dead and living fish were observed. Furthermore, degree of pigmentation of tail and body, pectoral fin development, eye and mouth development, and mobility were also noted. After this was done, 10 mL of liquid in each petri dish was removed and then replaced with the exact amount and concentration needed. The fish were also fed paramecium (one drop per dish) on days 4 and 7.
Data and Observations: Below is a table that summarizes what was observed. Detailed notes on physical appearance is also regarded.
| Days Past | Type | # of Dead Organisms | # of Living Egg Cases | # of Larvae | Stage | Length (in mm) | Visual Interpretation & Description |
| 7 | Control | 9 | 0 | 5 | 72 hour stage | ~1 mm | Long tail, really dark eye pigmentation, fins have developed for the most part, eyes are moving, little fins are developing & moving (near the fish's head), yolk absorbed, slightly protruding mouth, moving back and fourth (using fins to move), dark tail pigmentation & thick. |
| 7 | ½ Dose | 4 | 0 | 14 | 72 hour stage | ~1 mm | Skinnier tail than control; really really dark eye pigmentation (black), same fin development as control, slightly protruding jaw (less than control), more fidgety (keeps running into the wall), swimming side to side using tail & fin, no yolk, no eye movement, really slight tail pigmentation. |
| 7 | Full Dose | 8 | 0 | 7 | 72 hour stage | ~1 mm | Mobility is very spastic (using fins and tails to move side to side, but not moving very far); end of tail is what's propelling the fish forward; limited mobility; light pigmentation of tails; no eye movement and eyes seem significantly smaller & eyes are completely black; no yolk and pectoral fins are really skinny; flat jaw (not protruding). |
| 11 | Control | 5 | 0 | 0 | > 72 hour stage | ~2 mm | All dead; string-like pieces floating around, mold at center of plate, particles floating around plate. |
| 11 | ½ Dose | 14 | 0 | 0 | > 72 hour stage | ~2 mm | None alive, there are string-like particles floating around the plate & molds growing. |
| 11 | Full Dose | 7 | 0 | 0 | > 72 hour stage. | ~2 mm | Again they're all dead; string-like pieces and moldy caracases/particles floating around the plate. |
PICTURES BELOW:
Body/Tail pigmentation in experimental (FULL DOSE):

Curved Tail in experimantal (HALF DOSE):

Mold-like substances found in place of zebrafish:


Conclusion and Further Directions: Surprisingly, the number of fish we had on day 7 was significantly less than on day 4. What was surprising about this was we could not account for the fish (it was as though they disappeared). This may have to do with something like human error as other people were in the lab with our fish and may have mistaken our fish as theirs? Although we began to see some effects of the fluoride on the development of zebrafish, the organisms had begun to die faster than we had expected/intended. By day 7, differences between the experimental fish and control could be easily noticed. Where the control fish were maturing as expected, deformities were seen in the experimental fish (both the half dose and full dose). For example, the control fish had full better mobility, whereas the experimental fish were limited in their movements. Furthermore, the fins of the control were normal while the experimental fish had significantly smaller/thinner fins. In one case, the tail of the experimental fish (half dose) had a curved tail rather than straight (PICTURE ABOVE). In comparison, the pigmentation was more prominent in the control fish. Unfortunately, on day 11, all of the remaining fish had died. A strange substance (resembling mold, perhaps?) was found in each dish. In hindsight, it may have been more advantageous to use more concentrations of fluoride, such a a quarter dose and 3/4 dose, to compare with the two experimental groups already being tested. Regardless, there is enough data that can be used to understand some effects of fluoride on embryonic development.
03/03/15
Feb. 26, 2015 - 16S Sequence Analysis
Purpose: The main point of this lab was to use PCR sequencing to amplify the 16S rRNA gene found on bacteria. This gene sequence is incredibly diverse, and each sequence is unique to each species. The DNA sequences will help us identify the species of our bacteria.
Materials and Methods:After characterizing the bacteria from the hay infusion culture, two of which were from the nutrient agar plates and two that were from the tetracycline plates, settuing up for the Polymerase chain reaction (PCR) could begin. One colony of bacteria with the most complete charcterization will be chosen from the tetracycline plates and the same will be done for a colony from the nutrient agar plates. This goes as followed: 1) A single colony of bacteria will be placed into 100 microliters of water in a sterile tube. 2) This will then be incubated in 100 degrees Celsius for 10 minutes in a heat blaock. This process is known as denaturization in PCR. 3) The samples will then be placed in a centrifuge, going at 13,400 rpm for 5 minutes. 4) While the sample is being centrifuged, 20 microliters of primer/water mix to a labelled PCR tube. This is then mixed to disolve the PCR bead. 5) Five microliters of supernatant from the sample is transferred to the 16S PCR reaction. This is then placed in a PCR machine. 6) After a time lapse of about a week, the PCR products will be run through an agarose gel. If there is a product, the instructor will purify the DNA sequence which we can use to identify the species of our bacteria.
Data and Observations: We did end up having products that was purified. From that, we were given a DNA sequence of the two baceria we had chosen. The sequences are shown below:
MB47-For_16S_G06.ab1 NNNNNNNNNNNNNNNNNCTNNNCNTGCAGCCGAGCGGTAGAGATTCTTCGGAATCTTGAGAGCGGCGCACGGGTGCGGAA CACGTGTGCAACCTGCCTTTATCAGGGGAATAGCCTTTCGAAAGGAAGATTAATGCCCCATAATATATCATATGGCATCA TTTGATATTGAAAACTCCGGTGGATAAAGATGGGCACGCGCAGGATTAGATAGTTGGTAGGGTAACGGCCTACCAAGTCA GCGATCCTTAGGGGGCCTGAGAGGGTGATCCCCCACACTGGTACTGAGACACGGACCAGACTCCTACGGGAGGCAGCAGT GAGGAATATTGGACAATGGGTGAGAGCCTGATCCAGCCATCCCGCGTGAAGGACGACGGCCCTATGGGTTGTAAACTTCT TTTGTATAGGGATAAACCTACCCTCGTGAGGGTAGCTGAAGGTACTATACGAATAAGCACCGGCTAACTCCGTGCCAGCA GCCGCGGTAATACGGAGGGTGCAAGCGTTATCCGGATTTATTGGGTTTAAAGGGTCCGTANGCTGATGTGTAANTCANTG GTGAAATCTCACANCTTANCTGTGAAACTGCCNTTGATACTGCATGTCTTGAGTGTTGTTGAANTANCTGGAATAANTNN GTANCAGTGAAATGCCTANATATTACTTNNANCACNANGTGCTAANGCANGTTGGTANNCCNCNACTGACNCTGATNGAG NAAANCNTGGGNNAGCGAACANAANTNNATACCCTGGGGNNGTNNNCNNNAANNAANCTNANTCNNTTTTTNTCTTTCTC TTNCNNATACANNNNNANCCGANAAGNTNGCCNNCTNCCGGGTGGTGTTCTCCNTNNTNNNGATGNNNTCNNCTNNNNNN NNNNNCNGCCCCCCCNCAANNATTTNTANANNNNTATANNNTNNNANANCNNGCGGCCCCCTNTNTAANNGGNNNNGGGG GAGNNNNNNGNNNNNGTTTTCTATTATATNTNNNNCTNTNNNCCNCNNGNNCNGGGGGGGTTGTNTCTCCCNNCCAGAAC NNAANGANANTNTNCNNCANCAGCCNNNN
MB48-For_16S_H06.ab1 NNNNNNNNNNNNNNGCNNANNNTGNNANNNNNGCGGTANGANGGGANGCTTGCTCTNNGATTCAGCGGCGGACGGGTGAG TAATGCCTAGGAATCTGCCTGGTAGTGGGGGACAACGTTTCGAAAGGAACGCTAATACCGCATACGTCCTACGGGAGAAA GCAGGGGACCTTCGGGCCTTGCGCTATCAGATGAGCCTAGGTCGGATTAGCTAGTTGGTGAGGTAATGGCTCACCAAGGC GACGATCCGTAACTGGTCTGAGAGGATGATCAGTCACACTGGAACTGAGACACGGTCCAGACTCCTACGGGAGGCAGCAG TGGGGAATATTGGACAATGGGCGAAAGCCTGATCCAGCCATGCCGCGTGTGTGAAGAAGGTCTTCGGATTGTAAAGCACT TTAAGTTGGGAGGAAGGGCATTAACCTAATACCTTGGTGTTTTGACGTTACCGACAGAATAAGCACCGGCTAACTCTGTG CCAGCAGCCGCGGTAATACAGAGGGTGCAAGCGTTAATCGGAATTACTGGGCGTAAAGCGCGCGTANGTGGTTTGTTAAG TTGGATGTGAAAGCCCCGGGCTCAACCTGGGAACTGCNTTCNAAACTGNCNAGCTAGAGTATGGTANAGGGTGGTGGAAT TTCCTGTGTAGCNNTGAAATGCGTAGATATANGAANGAACACNNNGTGGCNAAGCGGACCACCTGNACTGATACTNACAC TGANNTGCGAAANNNTGTGGANCAAACANNATTANGATNNCCTNNAGTCCACNGCCNGTANACNNNNTCAACTANCNNNN NNAGCNCTTNANNTGTTANTGNCGCNNCTAACNCATTAANTNNCNNCGCTGGNTNNGTAGNAGNCCNCGNCCGTTAGNNC TNNNNNNGGAGTTNANNGGNGCCNNGCACAAGCNACTGNAGCAGGGNGGGNTGTAGTTCCNAANNNNNNACNAAAAANNN NNACCCNGNCCCTNGGNATNNAANNNAGNNNNNGAGGNNNNNNAANNNGNGNNNNGGNTGNNNNCNNNGGAAANNNNACC ANNNGNNNATGGTNGGNNNNNNNCNNCANNNNNNCNANCCCNNNNNNN
Conclusion:Using an online tool, we were able to determine the exact species of our bacteria. For the first sequence, we surmised that the species of bacteria was Chryseobacterium. Like we observed in our studies, chryseobacterium is gram negative, circular in shape and has limited motility (typically a gliding motion).There are many variations of this bacterium, including raw milk. The colors of the bacterium also vary, although it does include a creamy white shade, like we had seen. From the second sequence, we deduced that the species of bacteria was Pseudomonas aeruginosa. Pseudomonas is a gram negative, coccus or bacillus shape, with some motility. Like before, this is similar to what we observed therefore showing that the analysis identified the species correctly. Although the program used did a pretty thorough job of identifying the bacteria, it would have been more advantageous to know the exact species of the first bacterium.
4.7.15 Include gel image. SK
02/28/15
Feb. 19, 2015 - Zebrafish Experiments w/ Fluoride: Days 0-4
Purpose: The Purpose of these experiments on zebrafish is to learn about embryonic development and how it can be affected by external influences. In this lab, we learned about different embryonic stages and compared embryonic development in different organisms. For this particular set-up, the zebrafish will be tested with fluoride and will be examined for significant changes in embryonic development.
Materials and Methods: Prior to the set up of each groups' experiments, we were to observe different organisms, including starfish, chickens, and frogs, to note and comprehend the differences in their embryonic development. Afterwards, each group was to begin their experimentation on the zebrafish with their choice of independent variable. These independent variables (caffeine, salinity, nicotine, etc.) were chosen after reading a published article about the effect of these environmental factors on a certain organism. Then, each group was to create their own experiment (hypothesis, prediction, and experimental plan) to examine the affect of their chosen IV (independent variable). The focus for this experiment was to determine the affects of different amount of fluoride on the development of zebrafish. The experiment was set up like so: 1) Control group was set up with 20 mL of purified water (Deer Park) in a petri dish. 20 healthy and living zebrafish embryos were added to the petri dish. 2) the experimental dishes were set up. 3) The first petri dish had half the dose of fluoride available for use (10 mL of purified water and 10 mL/g of Fluoride). Like before, 20 translucent zebrafish embryos were transferred to the dish. 4) The last dish set up had the full dose of fluoride available (20 mL/g of fluoride) and 20 zebrafish were put into the dish. The study will take about two weeks. Every few days, the number of dead fish, number of embryos/larvae, length, and eventually heartbeat will measured (Quantitative data) as well as various physical details (eye and mouth development, etc.).
Data and Observations: The table below depicts the data collected on days 0, 1 and 4. Detailed notes on the physical appearances are also noted.
| Days Past | Type | # of Dead Organisms | # of Living Egg Cases | # of Larvae | Stage | Length (in mm) | Visual Interpretation & Description |
| 0 | Control | 0 | 20 | 0 | Most were in 8 or 16 cell stages. Two were in the 60 hr stage. | ~1 mm | Embryo is encased; rounded shapes at the top of the egg cases indicate the stages. |
| 0 | ½ Dose | 0 | 20 | 0 | Either in the 8 cell stage or the 16 cell stage. | ~1 mm | Embryo is encased; rounded shapes at the top of the egg cases indicate the stages. |
| 0 | Full Dose | 0 | 20 | 0 | Either in the 8 or 16 cell stage. | ~1 mm | Embryo is encased; rounded shapes at the top of the egg cases indicate the stages. |
| 1 | Control | 0 | 20 | 0 | All were in the 72 hour stage. | ~2 mm | Eyes have begun to develop and retina pigmentation is relatively dark. |
| 1 | ½ Dose | 1 | 19 | 0 | All were in 72 hour stage | ~2 mm | Eyes development and retina pigmentation is relatively dark. |
| 1 | Full Dose | 2 | 18 | 0 | All were in the 72 hour stage. | ~2 mm | Eyes development and darker retina pigmentation. |
| 4 | Control | 5 | 1 | 14 | Most fish are in the early larvae stage | ~4 mm | Longer tails, mobile, mouths are protruding, pec fins developing. |
| 4 | ½ Dose | 0 | 1 | 18 | Fish are in the early larvae stage. | ~3 mm | Longer Tails and fin development, mouths more noticeable, some are deformed with a more curved shape. |
| 4 | Full Dose | 3 | 0 | 15 | Early larvae stage. | ~3 mm | Deformities beginning to show (curved body vs. straight), otherwise similar to above. |
Days 0-4: **Zebrafish were 60 hours in age at the beginning of the process.
+/- 1 mm as it is very difficult to measure the moving organisms.
Below are pictures of the embryos from days 1 and 4.
 You can see the early stages of development in day 1.
You can see the early stages of development in day 1.
 These are the zebrafish from the control group on day 4.
These are the zebrafish from the control group on day 4.
Conclusions and Future Directions: According the the scientific article on fluoride on embryonic development, the fluoride does cause some stunts in growth which we are beginning to see. Because this experiment is time sensitive, more useful conclusion cannot be made until the very end. Nevertheless, changes can be noted until then.
Feb. 12, 2015 - Vertebrates and Niches in Transect 4
Purpose: The integral purpose of this exercise was to expand our perspective on our transect as well as understanding the ecological concepts that pertain to ecosystems everywhere. This would be the completion of our transect study.
Materials and Methods: In order to do this, we were to use our textbooks to learn about ecosystems, energy transfers and trophic levels. From this, we were to identify five invertebrates that inhabit our transect. It was also necessary to create a food web to show how each of the organisms related to each other via a food web.
Data and Observations: Below is that chart documenting some of the vertebrates found in our transect.
| Common Name | Phylum | Class | Order | Family | Genus | Genus |
| Squirrel | Chordata | Mammalia | Rodentia | Sciuridae | Sciurus | Sciurus Carolinesis |
| Robin | Chordata | Aves | Passeriformes | Turdidae | Turdus | Turdus Migratorius |
| Sparrow | Chordata | Aves | Passeriformes | Emberizadae | Melospiza | Melospiza Melodia |
| Five lined Skink | Chordata | Reptile | Squamata | Scinidae | Eumeces | Eumeces Fasciatus |
| Chipmink | Chordata | Mammalia | Rodentia | Sciuridae | Tamias | Tamias Striatus |
Each of these organisms are benefited by the transect. Squirrel: Food/vegetation availible when hungry (biotic) and can essentially use the land and plant beds to store nuts (abiotic). Robin and Sparrow: Seeds for/from plants can be used as a food source (biotic) and can use the mulch to build nest (abiotic). Chipmink: Bugs and vegetation can be used as food (biotic) and can borrow into plant beds or ground to serve as a home (abiotic). Five lined Skink: Bugs can be used as food (biotic) and can hide and camouflage itself from other predators in the soil (abiotic).
Below is a possible food web for Transect 4:

Conclusion: The organisms that have been found in transect four represent the ecological concepts of community, carrying capacity, and trophic levels. Trophic levels refer to the position an organism occupies on the food chain. They group organisms based upon their main nutritional source. Trophic level starts with primary producers, also known as organisms that make their own food. In our case, that would be the vegetation such as the lettuce and kale. Second would be the primary consumers, which are the herbivores such as the pseudo-scorpion. Third would be the secondary consumers that eat the primary consumers, an example of that in transect 4 would be the skinks or birds. Lastly, we have the tertiary consumers, which are the carnivores that eat the secondary consumers. The entire transect and the organisms that live there depict a community, which is when populations of different species interact together. Carrying capacity is a term that can be defined as the maximum population size that an ecosystem can sustain. It could not be determined by our studies if any of these species had reached carrying capacity. Closely observing and essentially dissecting our transect demonstrated that even areas where it may not seem to be diverse, they are incredibly biological diverse. This exercise served as the icing on the cake of our study.
02/18/15
Feb. 12, 2015 - Classifying Invertebrates
Purpose: The main purpose of this lab was to gain a thorough and better understanding of the importance of invertebrates via the burlese funnel. Furthermore, we were able to gain a wider perspective on the complexity of our individual transect.
Materials and Methods: The experiment here called for a number of procedures. Procedure one allowed us to observe Acoelomates, pseudocoelomates, and coelomates. By meticulously observing each of these organisms, we were able to see distinctions in each. Procedure two had us closely examine different arthropods since many invertebrates that reside in each transect would typically be from one of the five major classes of arthropods. In order to have found the invertebrates living in our transect, a burlese funnel method was utilized. Occasionally, it can be difficult to find invertebrates living in such frigid temperatures, nevertheless, many invertebrates can be found. The burlese funnel is set up as so:First, 25 mL of 50:50 water/ethanol solution is put in a 50 ML tube. Then a piece of screening material is taped onto the bottom of a funnel. The screen is necessary in that it prevents the leaf litter from falling and disturbing the preservative. The leaf litter sample is then placed on top of the funnel. Parafilm is wrapped around the base of where the funnel and tube meet. This serves a great importance as it prevents the ethanol from evaporating. Afterwards, a lighted 40 watt lamp is placed above the funnel at 1-2 inches away from the leaf litter. Everything is then covered with aluminum foil. The burlese funnel requires it to sit for at least one week.
Data and Observations: The table below shows the analyse of each invertebrate found residing in our transect. The size range of the invertebrates found are between 1 mm and 20 mm, which is relatively small. The largest was the scale/aphid while the smallest was the soil mite. Generally, not many examples of each organism could be identified but there was a large amount of soil mites found.
| Organism (Phylum and Class) | Length (in mm) | Number in Sample | Description of Organism |
| SPRINGTAILS Phylum: Athropoda Class: Hexopoda | ~10 mm | 2 | Antennae present, hair-like features, 3 to 6 legs per springtail, segmented body |
| SOIL MITES Phylum: Arthropoda Class: Arachnida | ~1 mm | 20 | Very Small, circular, non-segmented body, many present |
| PSEUDOSCORPIONS Phylum: Arthropoda Class: Arachnida | ~8 mm | 4 | Very small, segmented body, two piercers present |
| BEETLE LARVAE Phylum: Arhropod Class: Insecta | ~5 mm | 1 | Small, circular in shape, few legs/hair-like feaures |
| A SCALE OR APHID Phylum: Arthropoda Class: Insecta | ~20 mm | 1 | Rather large in size, striped, hair-like features, 6 legs, long antennae |
Pictures of each invertebrate are below:
Springtail:  Pseudoscorpion and soil mite:
Pseudoscorpion and soil mite:
Conclusions: The extensive amount of research and experimentation done on the transect have shown such amazing diversity in such a small area of land. The lab done here is proof of that. From this, we were able to broaden our outlook on biodiversity as a whole.
2.20.15 Excellent. Lots of details and good images. SK
02/15/15
Feb. 5, 2015 - Identifying and Understanding Plants and Fungi
Purpose: In this lab, the main objectives were understanding the characteristics and importance of both plants and fungi. By understanding the functions and characteristics of both plants and fungi, we will be able to have a better perspective on not only the importance of these organisms, but also the diversity of them as well.
Materials and Methods: This lab was divided into six sections, with a specific focus for each. The first part (procedure I) required that we collect five plants samples from our individual transect. The conditions for this procedure was to make sure that minimal damage would be done to the transect. We also were to take a leaf liter sample, in which we chose an area with soft soil and dead leaves and collected it for the Burlese funnel experiment that would be done the following week. The second procedure focused on plant vascularization, which helped us gain more insight to plant life. We were to compare rhizoids (moss) to angiosperms (xylem and phloem). This was first done with moss and a lily stem, and then taken a step further by looking at each of our plant samples from the transect and describing what vascularization they had. The third part called for us to use a microscope to closely view the presence of specialized structures of plants. The structures that were being focused on here were the stomata, cuticles, guard cells, mesophyll, parenchyma, and palisade mesophyll. Similar to the procedure before, we were to use our new knowledge to find specialized structures in the plant samples from our transect. The fourth procedure went through mechanisms of plant reproduction. There was quite a bit of focus on gametophyte (haploid) and sporophye (diploid) stages in the plant life cycle. A lily plants was dissected to gain a better understanding visually of reproduction in plants. Again, like the procedures before, using this new information, we were to identify the seeds from our transect and identify them as monocot or dicot. The fifth part of the lab was understanding and observing fungi. Looking at prepared slides, we were to identify the fungi as being either zygomycota, basidiomycota, and ascomycota. The last section of the lab, part six, was in preperation for next week's lab. The procedure was setting up the burlese funnel which is to collect invertebrates. When setting up the funnel, you need to pour 25 mL of ethanol/water solution in the 50 mL conical tube. Then, a screen material is placed and taped down on the bottom of the funnel. This is done to prevent any of the leaves from entering the preservative. Then, the leaf litter that was collected from the transect is put on top of the funnel. It is taped with parafilm that way the ethanol does not evaporate during the time allotted. After connected the funnel to a ring stand, a 40 watt lamp is placed 1-2 inches from the top of the leaf litter.
Data and Observations: Table 1: Plant Characterization
| Transect Sample Plants | Location and # in transect | Description (size and shape) | Vascularization | Specialized Structures | Mechanisms of Reproduction | ||||||
| Leaf and Brussel sprout head, large leaf, 19cm from stem to top, veins are crisscross, thick stem, wavy leaf, hard in texture, round head | Xylem and phloem | Chlorophyll, ovary and ovules | Alternation of Generations | ||||||||
| #1 | Third planter box, Brussel Sprouts | ||||||||||
| Thick stem, crisscross veins, curly/wavy leaves, hard in texture, large sized leaves, 11 cm from root to tip | Xylem and Phloem | Guard cells, stomata, chlorophyll | Alternations of Generations | ||||||||
| #2 | First planter box, Kale | ||||||||||
| Small stem, flat, veins are parallel to each other, soft in texture, smaller leaves, 9.5 cm from top of the leaf to bottom | Xylem and Phloem | Guard cells, stomata, chlorophyll | Alternations of Generations | ||||||||
| #3 | Fourth Planter Box, Lettuce | ||||||||||
| Short, similar sized root, one part red other part green, no veins visible | Xylem and Phloem | Chlorophyll, stomata, guard cells | Alternations of Generations | ||||||||
| #4 | Second planter box, Grass | ||||||||||
| Weed, many leaves, crisscross patterned veins, small in size, ~2.4 cm sized leaves, small ridges and rounded leaves | Xylem and Phloem | Chlorophyll, guard cells, stomata | Alternations of Generations | ||||||||
| #5 | Fourth planter box, Weed |
Here are the leaf samples taken from transect 4:
Overall transect:  Brussel Sprout sample:
Brussel Sprout sample:  Kale Leaf:
Kale Leaf: Lettuce leaf sample:
Lettuce leaf sample:  Weed sample:
Weed sample: 
We also observed fungi. Fungi can belong to three different groups and it was up to us to determine which group the chosen fungus belonged to. It is important to understand the significance of fungi sporangia. The fungi sporangia is a type of hyphae that grow upward and form structures called sporangia, which contain spores. These sporangia open and disperse the spores only when they are "matured".
The above fungus was classified as Ascomycota. This is because this type of fungus is typical in certain yeasts, mildews and molds and the sample we viewed was a bread mold.
Conclusions:
Clearly and amazingly, we can see how diverse the organisms really are. From studying small organisms and seeing the diversity with that group, it is amazing how diverse organisms are even in the macroscopic scale. Our transect has provided us with a much wider scope in which we can view that diversity in the world. Continuing with this, the burlese funnel will provide us with more information about the organisms living in our transect.
02/09/15
2.10.15 Very good and thorough notebook entry. I don't see in the text the results of the gram stain procedure. Did you decide whether your bacteria of interest were gram positive or negative? SK
Jan. 29, 2015 - Identifying & characterizing bacteria and setting up PCR
Purpose: In this particular lab, there were various objectives that were set to be accomplished. We were to identify and understand multiple characteristics of bacteria. Due to the agar plates (one with antibiotics and without) set up in the previous lab, we were to also understand antibiotic resistance in bacterial growth. Furthermore, at the end of the lab, we began a PCR process in order to comprehend how DNA sequences can aid in identifying species.
Materials and Methods: Before beginning any of the procedures, we were asked whether Archaea bacteria could have grown on the agar plates or not. This would be impossible considering Archaea bacteria grown in extreme condition such as in hot springs or in the depths of the ocean. Additionally, we were to observe any changes in appearance or smell in the hay infusion culture. In our culture, there were no real changes to the appearance or smell. One reason as to why the appearance or smell might change could be the growth of more bacteria or perhaps the plants included in the culture have begun to decompose which would affect the smell and appearance. Procedure 1 of the lab was quantifying and observing the bacterial colonies that had grown in each agar plate. Over the week, the bacteria from the hay infusion as well as some fungi had grown on the agar plates. Bacteria is known to grow exponentially, therefore reproducing millions of bacteria in a short span of time. The purpose of this procedure was to count and observe the number of colonies. Afterwards, in procedure 2, we observed antibiotic resistance in the agar plates. half of the agar plates have antibiotics (tetracycline) on them while the other half does not. Procedure 3 allows us to look more in depth at our plates and the bacteria that has proliferated. two plates with clear colonies were chosen, one plate with tetracycline and one without, and observed through a microscope. The colonies must be well isolated and for each of these samples, both a wet mount and a gram stain. The wet mount procedure requires a tiny amount of growth from a colony to be placed on a slide by a sterilized loop. Water is added on top of the growth and a cover slip is placed on top of that. Although this is far from difficult, finding the organisms via microscope proves to be a challenge because the organisms are not stained. The gram procedure allows us to stain the growth for a clearer perspective. This is done by putting a bit of growth on a slide with a sterilized loop and adding a drop of water. Afterwards the slide must be passed through an open flame to dry the slide. With a staining tray, the stain process can begin. This begins with covering the bacteria smear with crystal violet dye for one minute, then washing off with water. This is followed by covering the bacterial smear with Gram's iodine for one minute then rinsing off. The bacterial smear is decolorized with alcohol for approximately 30 seconds and then covered with safranin stain for an additional 30 seconds, which will be rinsed off with water. Excess water must be blotted off before putting it under a microscope. Coverslips are NOT needed for this! Oil immersion might be necessary when changing the objective lens from 40X to 100X. Lastly, procedure 4 is setting up the PCR for 16S sequencing. One of the characterized bacteria from each plate (tetracyline plate and nutrient agar plate) will be used. The DNA from the bacteria will be isolated in order to amplify the 16S rRNA gene. This is done by first, transffering a single colony of bacteria to 100 micro liters of water in a sterile tube. Then the tube is incubated at 100 degrees Celsius for 10 minutes in a heating block. Next, the the samples are spun in a centrifuge for 5 minutes. During this stage, 20 micro liters of primer is added to a labeled PCR tube. Five microliters of supernatant are then transferred to the 16S PCR reaction and placed in the PCR machine.
Data and Observations:The following is the results from the 100-fold serial dilutions in procedure 1 ~
| Dilution | Agar Type | Colonies Counted | Conversion Factor | Colonies/mL |
| 10^-3 | Nutrient | 37 | X103 | 370000 |
| 10^-5 | Nutrient | 17 | X105 | 17000000 |
| 10^-7 | Nutrient | 1 | X107 | 100000000 |
| 10^-9 | Nutrient | 0 | X109 | 0 |
| 10^-3 | Nutrient +Tetracycline | 14 | x103 | 14000 |
| 10^-5 | Nutrient + Tet | 0 | X105 | 0 |
| 10^-7 | Nutrient + Tet | 0 | X107 | 0 |
| 10^-9 | Nutrient + Tet | 0 | X109 | 0 |
Procedure 2 found it essential that we understand antibiotic resistance. It is clear that the agar plates that didn't have tetracycline had a greater amount of bacterial growth. Only one plate with tetracycline had growth, whereas three of the nutrient agar plates had growth.
Procedure 3 The table below is the observations of the plates after the gram staining process.
| Colony Label| | Plate Type| | Colony Description| | Cell Description| | Gram +/- |
| White | 3-Oct | Colony is small, white and circular. The surface can be described as smooth and flat in elevation, and edges were mainly entire, some were undulated. It has a diameter of approx. 0.5 cm. | Cells were vibrating, close together and circular in shape. 10 micrometer at 40X objective. | + |
| Yellow | 3-Oct | Small, circular colony that is generally smooth and shiny with a flat elevation. In terms of shape, they were irregular with filamentous edges and a wrinkled surface. Approximately 0.5 cm in diameter. | Cells are long in length and rod shaped, arranged in long strips (like sausages). Not motile, and look like raise palisades. 1 micrometer at 100X objective. | + |
| White | T10-3 | Circular in shape with a smooth surface, while edges are entire and elevation is convex. Small in size~ approximately .2 cm in diameter. | Cells are arranged in string-like patterns. Shapes are primarily circular while some are ovular. Close resemblance to streptobacilli.5 micrometers at 40x. | - |
| Yellow | T10-3 | Colony is small and circular. Edges are entire, surface is smooth and slightly shiny, while the elevation is convex. Is approximately .5 cm in diameter. | Shape can be described as coccus and circular. Single/isolated, no groups present through culture, not motile. Few cells present on the slide. 4 micrometers at 40x. | + |
Below are pictures of the plates used:
This is the 10^-3 plate with tetracycline used.
This is the 10^-3 plate with tetracycline used.
This is the 10^-3 plate used .
This is the 10^-3 plate used .
Additionally, here are pictures of some of the slide after going through the staining process.
 This shows a gram negative image. Notice how the space that is in the shape of a bird did not retain any of the dye.
This shows a gram negative image. Notice how the space that is in the shape of a bird did not retain any of the dye.
 This depicts a gram postive image as the entire thing has kept the dye.
This depicts a gram postive image as the entire thing has kept the dye.
Conclusions and Future Directions: After observing the bacerial growth on our plates, it was clear to see that the plates without tetracycline allowed for more growth. This is because the genes present in the bacteria can either survive the antibiotic or die from it. The genes in the one plate that had actual growth was clearly antiiotic resistance, making it more fit to survive. With the PCR process, we will be able to see the DNA sequence for our bacteria and actually identify it, which could increase our understanding of the antibiotic resistance.
02/03/13
2.4.15 Very good notebook entry. Included detailed description of Hay infusion and identified protists. Nicely organized. Pictures are rather large. SK
Jan. 22, 2015 - Hay Infusion Observations and Serial Dilutions
Purpose: The primary purpose in this lab was to observe and identify living microorganisms found in the particular transect by utilizing a dichotomous key. The organisms were a result from the hay infusion, which can be considered its own ecosystem. Furthermore, these microorganisms play a certain role even within the hay infusion ecosystem.
Materials and Method: Before assessing the hay infusion of the assigned transect, some practice on using a dichotomous key was done. This was to ensure that all parties were clear on how to use a dichotomous key to determine an organism. Afterwards, the hay infusion observations were done. In order to do this, each group was to carefully, without any disturbances, move the culture, and assess its smell and appearance. Then, samples were taken from different areas in the culture and assessed through a microscope. The main intention was to find protists within the culture, using a dichotomous key.
Subsequently, serial dilutions were prepared and plated in order to closely examine the bacteria in the hay infusion. This was done by taking broth and putting it into 4 test tubes labeled 10^-2, 10^-4, 10^-6, and 10^-8. Then 100 microliters of culture was taken and put into the first tube labeled 10^-2, and from that test tube 100 microliters of solution was taken and out into the test tube labeled 10^-4., so on and so forth. Once this was done, 100 microliters of the solution in test tube 10^-2 was plated on the agar plates labeled 10^-3, so on and so forth. One set of plates were nutrient agar and the other set was nutrient agar and tetracycline.Diagram below:

Data and Observations: In transect four, the hay infusion made was brown in color yet relatively clear in that you could easily see the bottom of the jar. The odor is best described as musty and no apparent signs of life could be seen.
The samples taken were from two different areas: very bottom of the jar and the top. On the bottom of the jar, we were able to find various protists inhabiting the culture including arcella (63 micrometer in length), paranema (45 micrometer in length), and paramecium (35 micrometers in length). All were motile, easily shown as they had mechanisms such as cilia or flagella that made them mobile. None were photosynthetic, as they were colorless and had no chlorophyll (no green pigmentation present).
Paranema image:
 In the top sample, different organisms were found including colpidium (51 micrometers in length), chilomanas (22 micrometers in lenght), and lastly paramecium aurelia (which was the largest at 156 micrometers in length). All of these were protozoa and non were photosynthetic. They were all motile, demonstrating mechanisms that made them so (presence of cilia or flagella).
Paramecium image:
In the top sample, different organisms were found including colpidium (51 micrometers in length), chilomanas (22 micrometers in lenght), and lastly paramecium aurelia (which was the largest at 156 micrometers in length). All of these were protozoa and non were photosynthetic. They were all motile, demonstrating mechanisms that made them so (presence of cilia or flagella).
Paramecium image:
 Conclusions and Further Directions: This lab depicted how diverse an ecosystem can be although it may not seem promising just by looking at it. Also, organisms occupy different niches in ecosystems, regardless of the size of the ecosystem. Moreover, due to the location, certain organisms will live in certain places while other do not. This was the case with transect four's hay infusion as different organisms were found in different locations. All of the organisms inspected has been protists. One of these was the paramecium aurelia. The paramecium aurelia meets all the needs of life. If the hay infusion culture was to "grow", I would expect for there to be more organisms present as the protists present now would have had time to reproduce. Additionally, I would think that organisms would change due to selective pressures placed on them. For example, if perhaps those organisms living near the leaves needed those leaves to survive, they could very well eventually die out as the leave begin to decay.
Conclusions and Further Directions: This lab depicted how diverse an ecosystem can be although it may not seem promising just by looking at it. Also, organisms occupy different niches in ecosystems, regardless of the size of the ecosystem. Moreover, due to the location, certain organisms will live in certain places while other do not. This was the case with transect four's hay infusion as different organisms were found in different locations. All of the organisms inspected has been protists. One of these was the paramecium aurelia. The paramecium aurelia meets all the needs of life. If the hay infusion culture was to "grow", I would expect for there to be more organisms present as the protists present now would have had time to reproduce. Additionally, I would think that organisms would change due to selective pressures placed on them. For example, if perhaps those organisms living near the leaves needed those leaves to survive, they could very well eventually die out as the leave begin to decay.
01/29/15
2.11.15 Good notebook entry. Well organized and clear. Missing a diagram of the transect. SK
Jan. 15, 2015 - Primary Observations for Transect 4
Purpose:This is a current and progressing experiment that allows students to observe a particular ecosystem within American University. From these ecosystems, students will gradually learn the importance of different organisms (such as animals, plants, and bacteria) and their niches in an ecosystem. The main purpose of this lab is to demonstrate the relevance of diversity within an ecosystem.
Materials and Methods: Each group was assigned a specific 20 X 20 transect, a section of land meant to represent an ecosystem. In this group, transect 4 was assigned. The group was to carefully observe and record aspects of the transect, including but not limited to: biotic and abiotic features, animals, plants, etc. Variables that could affect later observations in the transect include human activity. Because this particular transect was the university's community garden, it would be open to human disturbance. Temperature/weather is also an important variable as the transect is being observed during colder temperatures (i.e. wintertime). The initial observation was followed by a hay infusion, which allowed students to take a 50 mL sample of soil and ground vegetation that would fully represent the entirety of the transect.
Data and Observations:Transect 4 is located near the back end of the university and is fenced completely around making it comparatively isolated. Nevertheless, due to this transect being the university garden, it is no stranger to human disruption. The transect is well kept and has various different vegetables growing such as broccoli, kale, corn and cucumber. Each crop is separated according to type and have been put in boxes. These plants were well watered through a watering system that had been set up. Certain plants had shown more growth while others had either little to no growth.
The abiotic (non-living) features of the transect include hay, mulch, soil, rocks and water (from the irrigation system). The hay, mulch and rocks were present nearly everywhere except for the plant beds, while rocks, soil and water were more apparent in the plant beds. The biotic (living) factors included vegetables, birds, squirrels, earthworms, and grass. The vegetables were clearly in their planting beds. Animals, such as the birds and squirrels made some frequent appearances on the transect, while others like the earthworms stayed within the soil. Grass, like the hay and mulch of the abiotic factors, was mainly on the ground, separate from the plant boxes. For the hay infusion, soil from each plant bed as well as the ground were taken as was grass, hay and mulch. This ensured that the hay infusion would be a good representation of the entire transect.
Conclusions and Future Directions:The fourth transect will continue to be monitored by the group members. It is clear that a glance at this transect would not suffice to show how diverse the life present is. Only careful and precise observations would show that. Later on, the hay infusion should be able to reveal more about the life present on this transect.
01/26/15
First Post
Hi, This is Libin :)
01/22/15




